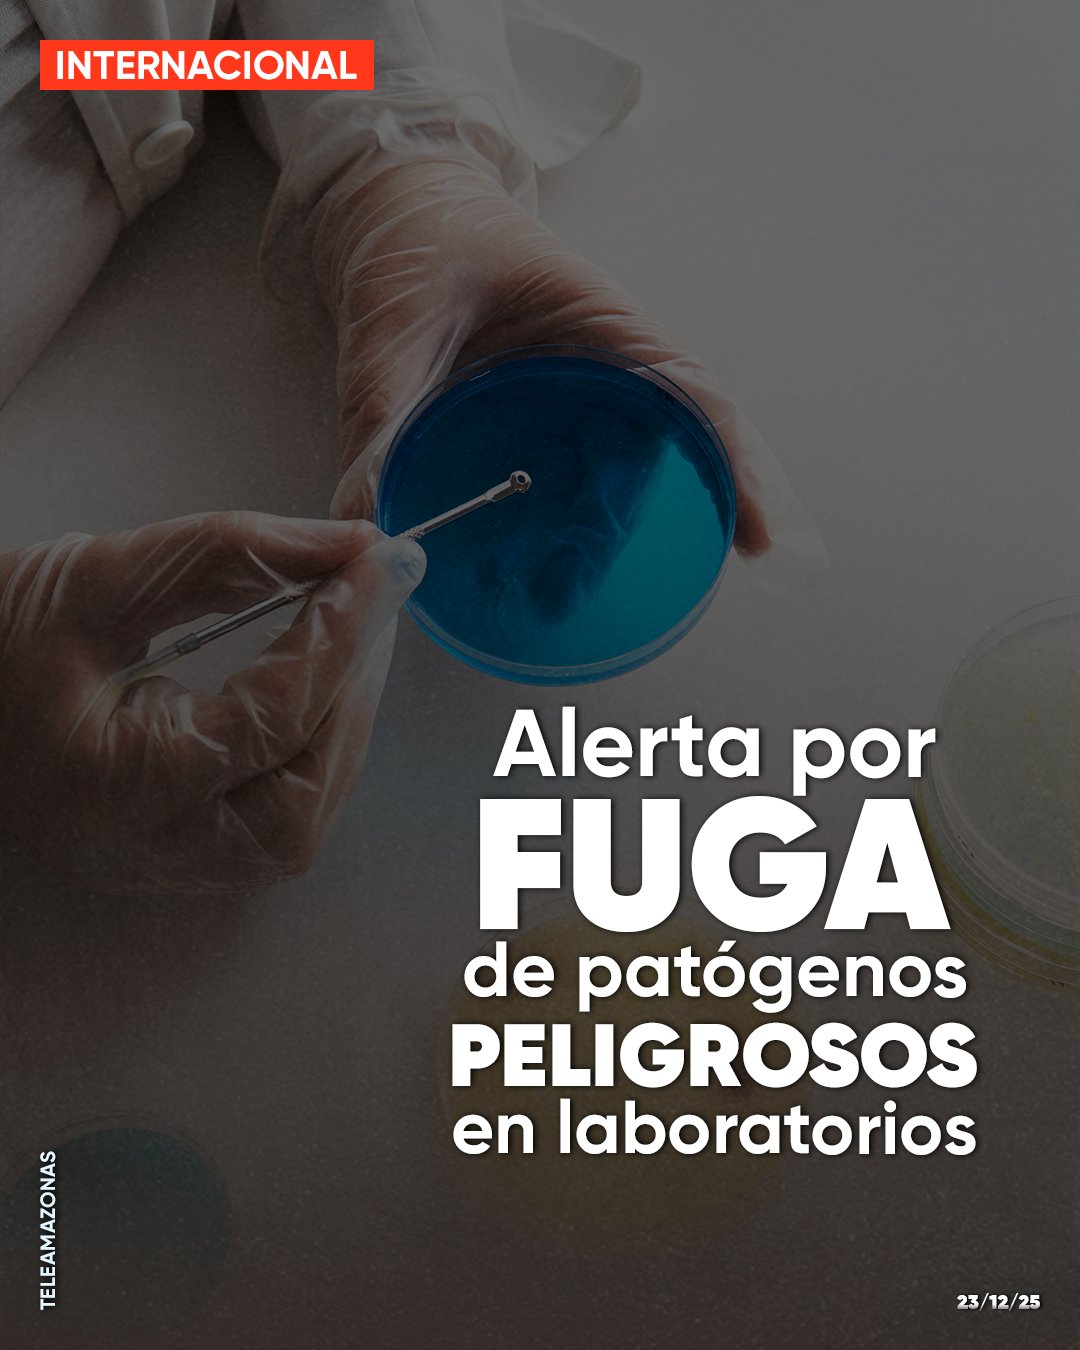

Cientos de accidentes exponen el riesgo "catastrófico" por fuga de patógenos de laboratorios ¿peligro para los humanos?
Cientos de accidentes exponen el riesgo "catastrófico" por fuga de patógenos de laboratorios ¿peligro para los humanos?
Cientos de accidentes exponen el riesgo "catastrófico" por fuga de patógenos de laboratorios ¿peligro para los humanos?